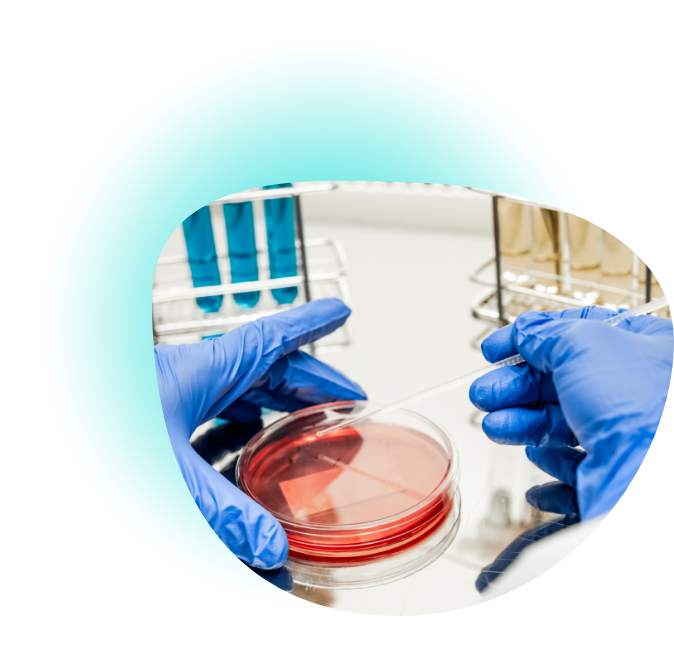
Servicio de bacteriología propio
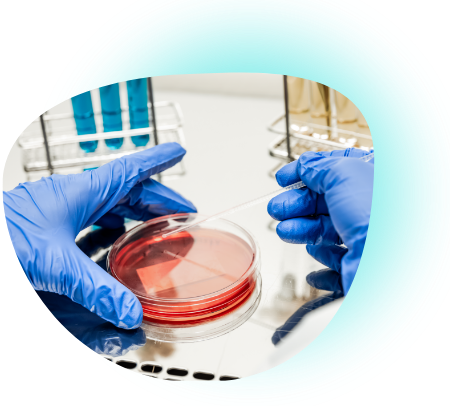
Servicio de bacteriología

DUOLAB
Es un laboratorio al servicio de tu salud, dedicado al diagnóstico bioquímico, molecular y bacteriológico.
DUOLAB
Es un laboratorio al servicio de tu salud, dedicado al diagnóstico bioquímico, molecular y bacteriológico.
Contamos con un equipo multidisciplinario altamente calificado, metodología y tecnología de vanguardia, con el objetivo de garantizar exactitud y precisión de los resultados para una adecuada valoración médica.
Para realizar tus análisis en DUOLAB
Estudios
¡En DUOLAB realizamos más de 2.000 estudios! Nuestras áreas de trabajo son: